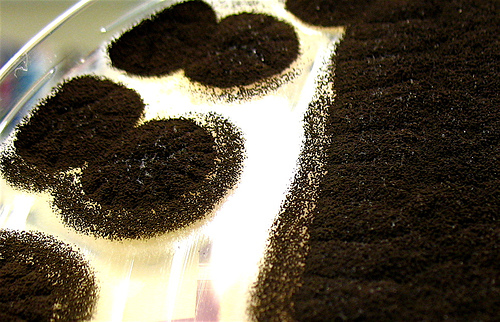

LearnThatWord and the Open Dictionary of English are programs by LearnThat Foundation, a 501(c)3 nonprofit.
Questions? Feedback? We want to hear from you!
Email us
or click here for instant support.
Copyright © 2005 and after - LearnThat Foundation. Patents pending.